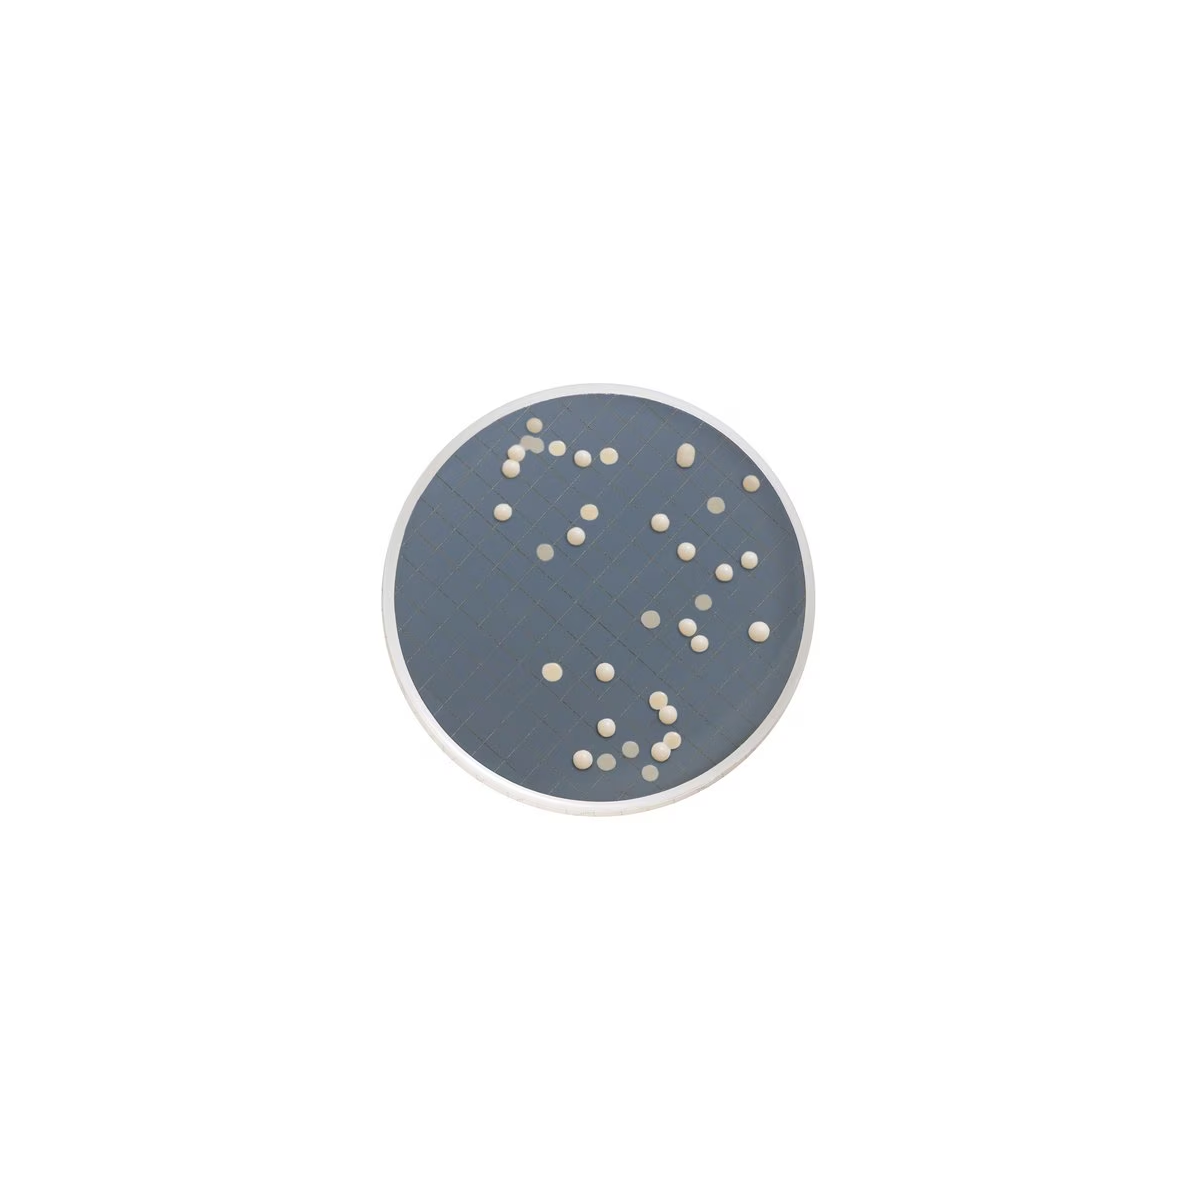

1
/
/
1
SKU-koodi:MXSMCSD48
Merck Life Science
Milliflex SDA Agar
Milliflex SDA Agar
Tilapäisesti loppu varastosta tai tilaustuote. Asiakaspalvelumme antaa tarkemman toimitusaikaarvion.
Tuotteen kuvaus
Tuotteen kuvaus
Sabouraud Dextrose Agar, for yeasts, for molds, pack of 48 tests, suitable for bioburden testing, Replacement item for MMSMCSD48.
Lisätietoja
Lisätietoja
Lataukset / käyttöohjeet
Lataukset / käyttöohjeet